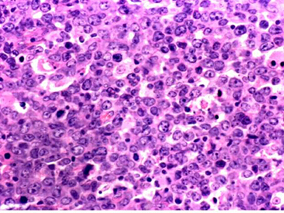
来那度胺联合R-ESHAP治疗复发或难治性DLBCL可行

-
来那度胺联合R-ESHAP治疗复发或难治性DLBCL可行
环球医学资讯
 2016年05月04日
2016年05月04日 点击量:1250
点击量:1250 1小时条评论
1小时条评论含利妥昔单抗治疗失败的弥漫性大B细胞淋巴瘤患者使用目前的挽救方案具有较差的结局。2016年4月,发表在《Br J Haematol》的GELTAMO组的1b期研究结果显示,来那度胺联合R-ESHAP(LR-ESHAP)方案可行,并且能产生令人鼓舞的结局。 含利妥昔单抗治疗失败的弥漫性大B细...
-
糖尿病或降糖治疗是否增加绝经后女性甲状腺癌风险?
环球医学资讯
 2016年04月26日
2016年04月26日 点击量:251
点击量:251 1小时条评论
1小时条评论糖尿病和甲状腺疾病是内分泌代谢系统中最常见的两大类疾病。研究表明,糖尿病患者容易出现甲状腺功能异常,合并甲状腺自身抗体阳性者的比例增加,而且比非糖尿病患者更易罹患甲状腺结节和甲状腺癌。2016年3月,发表在《J Clin Endocrinol Metab》的一项研究却并不支...
-
来曲唑可安全地与辅助性乳腺放疗同步给予
环球医学资讯
 2016年04月22日
2016年04月22日 点击量:153
点击量:153 1小时条评论
1小时条评论2016年3月,发表于《Ann Oncol》的一项报告了CO-HO-RT II期随机试验的最终结果。该试验考察了来曲唑共同或序贯给药辅助性乳腺放疗的安全性和有效性。结果显示,来曲唑能安全地与辅助性乳腺放疗同步给予。 背景:我们将COHORT试验和平移亚组研究的最终临床结果呈现在...
-
非鳞状非小细胞肺癌:培美曲塞-顺铂+TRT+培美曲塞强…
环球医学资讯
 2016年04月22日
2016年04月22日 点击量:624
点击量:624 1小时条评论
1小时条评论2016年3月,发表于《J Clin Oncol》的一项PROCLAM研究考察了了局部晚期非鳞状非小细胞肺癌患者使用培美曲塞-顺铂或依托泊苷-顺铂联合胸部放疗随后巩固性化疗的有效性。 目的:PROCLAIM III期研究评估同时培美曲塞-顺铂和胸部放疗(TRT)随后巩固性培美曲塞的总生存...
-
具有单一不可治愈因素的晚期胃癌:胃切除术无效
环球医学资讯
 2016年04月22日
2016年04月22日 点击量:173
点击量:173 1小时条评论
1小时条评论化疗是不可治愈的晚期胃癌的标准治疗方法。将胃切除术加入到化疗中是否可以改善具有单一不可治愈因素的晚期胃癌患者的生存率仍存在争议。2016年3月,发表在《Lancet Oncol.》的一项国际随机试验研究表明,胃切除术联合化疗不能改善具有单一不可治愈因素的晚期胃癌患...
-
欧洲指南:早期乳腺癌可使用辅助双磷酸盐治疗
环球医学资讯
 2016年04月21日
2016年04月21日 点击量:491
点击量:491 1小时条评论
1小时条评论双磷酸盐常用于防治乳腺癌患者因使用芳香化酶抑制剂而产生的骨折等副作用。2016年3月发表在《Ann Oncol》的一项由德、英、法等国科学家组成的欧洲专家小组发表的共识指南指出,早期乳腺癌可使用辅助双磷酸盐治疗。 随机试验已经对双磷酸盐治疗早期乳腺癌进行了研究...
-
转移性非透明细胞肾细胞癌:依维莫司vs舒尼替尼
环球医学资讯
 2016年04月21日
2016年04月21日 点击量:220
点击量:220 1小时条评论
1小时条评论肾细胞癌是最常见的恶性肾脏肿瘤,约占肾癌总患者的85%。2016年3月发表在《Lancet Oncol》的一项由美国、英国、加拿大科学家进行的研究表明,转移性非透明细胞肾细胞癌患者中,与依维莫司相比,舒尼替尼能改善无进展生存期。 背景:非透明细胞肾细胞癌是组织学和基...
-
利妥昔单抗暴露的非霍奇金淋巴瘤存活者的二次原发性…
环球医学资讯
 2016年04月21日
2016年04月21日 点击量:371
点击量:371 1小时条评论
1小时条评论利妥昔单抗适用于复发或耐药的滤泡性中央型淋巴瘤的治疗。2016年3月发表在《Ann Oncol》的一项由法国、荷兰、德国等国科学家进行的系统评价和荟萃分析表明,利妥昔单抗暴露的非霍奇金淋巴瘤存活者中,未发现二次原发性恶性肿瘤倾向。 背景:将抗CD20单克隆抗体利妥...
-
总生存期以外的终点对抗癌药物监管部门获批有无必要
环球医学资讯
 2016年04月21日
2016年04月21日 点击量:268
点击量:268 1小时条评论
1小时条评论2016年3月,发表在《Ann Oncol》的一项由巴西和比利时科学家进行的综述表明,终点以外的总生存期对抗癌药物的监管部门获准是必要的。 癌症临床试验中,总生存期(OS)的相对指标和其他能用于首要终点的指标一直存在争论。虽然生存期是争论最多的用于评估癌症治疗有...
-
口腔炎是否影响依维莫司对实体瘤和结节性硬化症患者…
环球医学资讯
 2016年04月20日
2016年04月20日 点击量:540
点击量:540 1小时条评论
1小时条评论口腔炎是哺乳动物雷帕霉素抑制剂类药物常见的不良反应。但2016年3月,发表在《Ann Oncol》的一项研究证实,对于实体瘤和胰腺神经内分泌瘤患者,口腔炎不会给PFS带来不利影响。 背景:依维莫司为一种口服哺乳动物雷帕霉素靶向(nTOR)抑制剂,被用于治疗实体瘤和结节...

会员登录
会员登录

